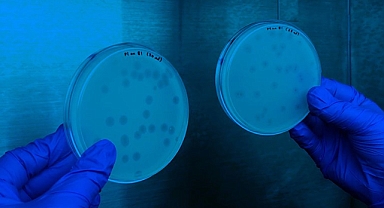
ABD'de gizemli hastalık

Forbes '2023 Dünyanın En Güçlü Kadınları' listesini yayınladı: Listede bir de Türk var
Forbes 2023 Dünyanın En Güçlü Kadınları listesinde Taylor Swift ve Beyoncé gibi bu yıla damga vuran isimler öne çıktı. Öte yandan listede yer alan tek Türk bu yıl da Güler Sabancı oldu.
Dünyanın en prestijli ekonomi dergilerinden biri olan Forbes, ‘2023 Dünyanın En Güçlü Kadınları’ listesini yayınladı. Listenin ilk sırasında Avrupa Komisyonu Başkanı Ursula von der Leyen, ikinci sırada Avrupa Merkez Bankası Başkanı Christine Lagarde, üçüncü sırada ise Amerika Birleşik Devletleri Başkan Yardımcısı Kamala Harris yer aldı.
19 YILDIR LİSTENİN DEĞİŞMEYEN İSMİ
Geçen yıl listede 81. sırada bulunan iş insanı Güler Sabancı, bu sene 77. sıraya yükseldi. Derginin internet sitesinde yer alan açıklamada, Sabancı Holding Yönetim Kurulu Başkanı Sabancı’nın Sabancı Vakfı ve Sabancı Üniversitesi'nde de Mütevelli Heyeti Başkanı olduğu hatırlatılırken, European Round Table for Industry'nin (ERT) ilk kadın üyesi olduğu vurgulandı. Ayrıca MIT Energy Initiative'in Dış Danışma Kurulu’nda görev aldığı belirtilen Sabancı, 19 yıldır listede yer alarak büyük bir başarıya imza attı.

YORUMLAR